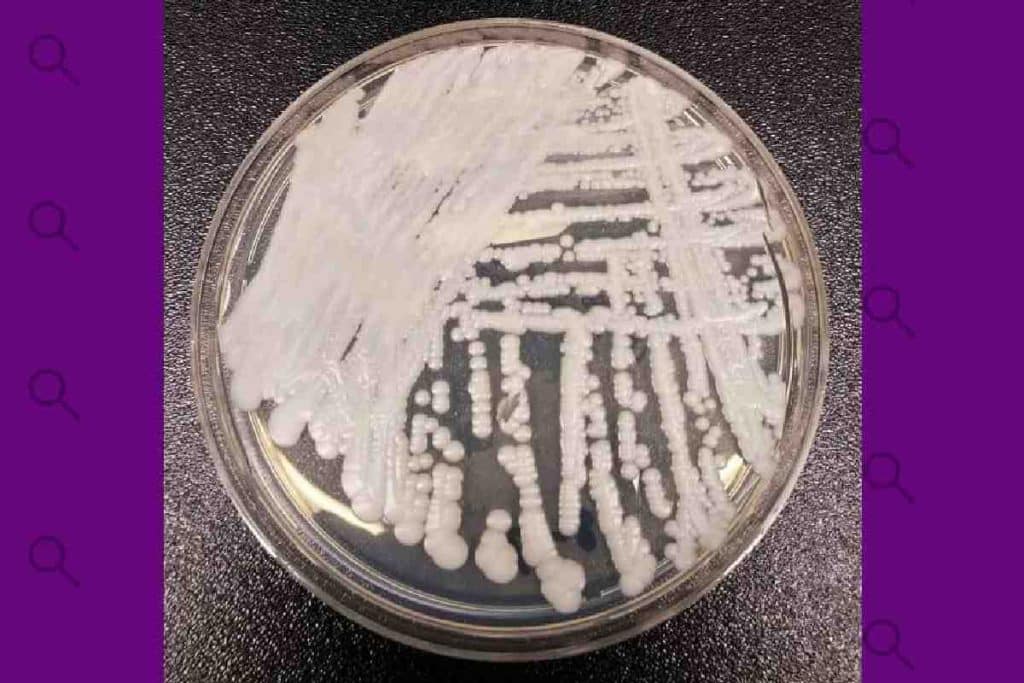
Con resistencia a los fármacos: el hongo ‘Candida auris’ que alerta a los especialistas en salud

Con resistencia a los fármacos: el hongo ‘Candida auris’ que alerta a los especialistas en salud
Las búsquedas en Google en Estados Unidos sobre ‘superbug fungus Candida auris’ (hongo superbacteria Candida auris, en español) se dispararon entre el 31 de diciembre de 2025 y el 2 de enero de 2026, según Google Trends. La Candida auris (C. auris) es un hongo que puede causar infecciones graves y que las autoridades sanitarias consideran una amenaza para la salud mundial. Este aumento de búsquedas se produjo en un contexto de expansión del hongo en varios estados del país. De hecho, al menos 28 estados de Estados Unidos ya han reportado casos, según los CDC, encargados del control de enfermedades. Te contamos todo lo que sabemos al respecto.

Búsquedas en Google en Estados Unidos de “hongo superbacteria Candida auris”.
¿Cómo se propaga?
Este hongo puede propagarse a través del contacto con superficies o equipos contaminados en entornos de atención médica o de persona a persona. Así lo indican los CDC, encargados del control de enfermedades, y destacan que se necesitan más investigaciones para comprender mejor su propagación.
¿Cuáles son los síntomas de la infección?
Los pacientes que tienen una infección por C. auris a menudo ya están muy enfermos, por lo que es difícil diferenciar los síntomas de la infección de los que padecen por otras patologías, según Medline Plus, el servicio de la Biblioteca Nacional de Medicina de Estados Unidos.
El Departamento de Salud de Minnesota afirma que los síntomas más comunes son fiebre y escalofríos que no mejoran después del tratamiento por sospecha de infección bacteriana.
¿Qué tipo de infecciones puede causar C. auris?
C. auris causa infecciones del torrente sanguíneo, de heridas o del oído, según los CDC. También se ha aislado de muestras respiratorias y de orina, pero aún no está claro si causa infecciones en los pulmones y la vejiga.
En algunos pacientes, al ingresar al torrente sanguíneo, puede diseminarse por todo el cuerpo y causar infecciones invasivas graves que, en el peor de los casos, pueden provocar la muerte.
De hecho, más de 1 de cada 3 pacientes fallecen en el primer mes después de haber recibido el diagnóstico de una infección invasiva por C. auris, según los CDC. No obstante, muchas de estas personas tenían otras enfermedades graves que también aumentaban su riesgo de muerte.
¿Cómo se diagnostica la infección?
Las infecciones por C. auris generalmente se diagnostican mediante un cultivo de sangre u otros fluidos corporales. Así lo indican los CDC, que señalan que este hongo es más difícil de identificar a partir de cultivos que otros tipos más comunes de Candida y que, para ello, se necesitan pruebas de laboratorio especiales.
¿Cómo se tratan las infecciones por C. auris?
La mayoría de las infecciones por C. auris se pueden tratar con unos fármacos llamados equinocandinas, como señalann los CDC. Sin embargo, algunas “han sido resistentes a las 3 clases principales de medicamentos antimicóticos, lo que las hace más difíciles de tratar”. En ese caso, según el organismo, es posible que se requieran múltiples tipos de antimicóticos en dosis altas para tratar la infección.
¿Quién tiene un mayor riesgo de infectarse?
C. auris a menudo infecta a personas hospitalizadas con frecuencia o que viven en hogares de ancianos, según el Departamento de Salud de Virginia: “Es más probable que afecte a pacientes que tienen sistemas inmunitarios debilitados debido a afecciones como cáncer de sangre o diabetes, que reciben muchos antibióticos o que tienen dispositivos como tubos que se introducen en el cuerpo (por ejemplo, tubos para respirar, tubos para la alimentación, catéteres en una vena o sondas vesicales)”.
Las personas sanas, según el organismo, generalmente no contraen estas infecciones.
¿Qué significa ser colonizado?
Este hongo también puede vivir en la piel u otras partes del cuerpo sin enfermar a la persona, según el Departamento de Salud de Virginia. A esto se le llama ser “colonizado”. Por ello, si alguien ha estado cerca de un paciente infectado por C. auris, su proveedor de atención médica podría realizarle pruebas para comprobar si es portador del hongo.
Quienes están colonizados pueden transmitir el hongo a otras personas. Además, también corren el riesgo de contraer la infección y enfermar más adelante, como indica Medline Plus, el servicio de la Biblioteca Nacional de Medicina de Estados Unidos.
¿Cómo se puede prevenir la infección por Candida auris ?
Para prevenir la infección por C. auris, tanto el Departamento de Salud de Virginia como MedlinePlus aconsejan lavarse las manos regularmente con agua y jabón o con un desinfectante a base de alcohol. Lo ideal sería hacerlo antes y después de estar en contacto con personas que tienen esta infección, y antes y después de tocar algún objeto en su habitación.
Además, recomiendan que si un ser querido está infectado, se aísle de otras personas y permanezca en una habitación separada. “Si está visitando a un ser querido que ha sido aislado de otros pacientes, por favor siga las instrucciones de los trabajadores de atención médica acerca del procedimiento para ingresar y salir de la habitación para minimizar la probabilidad de diseminar el hongo”, añaden desde MedlinePlus.
¿Por qué preocupa ‘C. auris’ a los organismos sanitarios?
Este hongo preocupa a organismos como los CDC por varias razones. Para empezar, según destacan varias investigaciones y la Organización Mundial de la Salud (OMS), muestra una amplia resistencia innata y adquirida a los fármacos. “Algunas cepas son resistentes a las 3 clases de antifúngicos disponibles”, explica el organismo.
Además, “es difícil de identificar con métodos de laboratorio estándar y puede identificarse erróneamente en laboratorios sin tecnología específica” y ha causado brotes en entornos de atención médica.
¿Dónde se han producido infecciones por C. auris?
Los científicos descubrieron C. auris por primera vez en Japón en 2009, según el Departamento de Salud de Virginia. Desde entonces, este tipo de infecciones se han detectado en más de 30 países. Así lo indican los CDC, que destacan que probablemente no se hayan notificado más infecciones en otros lugares debido a que, para identificar el hongo, se necesitan métodos de laboratorio especializados.
En Estados Unidos, C. auris se identificó por primera vez en 2016, según un estudio publicado en Annals of Internal Medicine. Los autores destacan que los casos y la transmisión de este hongo aumentaron notablemente entre 2019 y 2021.
En 2025, Candida auris infectó a más de 7,000 personas en Estados Unidos. Así lo indican los CDC en esta web, en la que puedes consultar una tabla que recoge cuántas infecciones se produjeron en cada estado.
Factchequeado es un medio de verificación que construye una comunidad hispanohablante para contrarrestar la desinformación en Estados Unidos. ¿Quieres ser parte? Súmate y verifica los contenidos que recibes enviándolos a nuestro WhatsApp +16468736087 o a factchequeado.com/whatsapp.
window.dataLayer = window.dataLayer || []; dataLayer.push({‘type’: ‘external’}); dataLayer.push({“destination”: “https://factchequeado.com/teexplicamos/20260105/hongo-candida-auris-resistente-farmacos/”}); dataLayer.push({“title”: “Qué sabemos del hongo ‘Candida auris’ resistente a los fármacos del que alertan las autoridades de salud”}) function gtag(){dataLayer.push(arguments);} gtag(‘js’, new Date()); gtag(‘config’, ‘G-VFW0Y02WRH’);
Comentarios (0)
No hay comentarios en esta publicación.